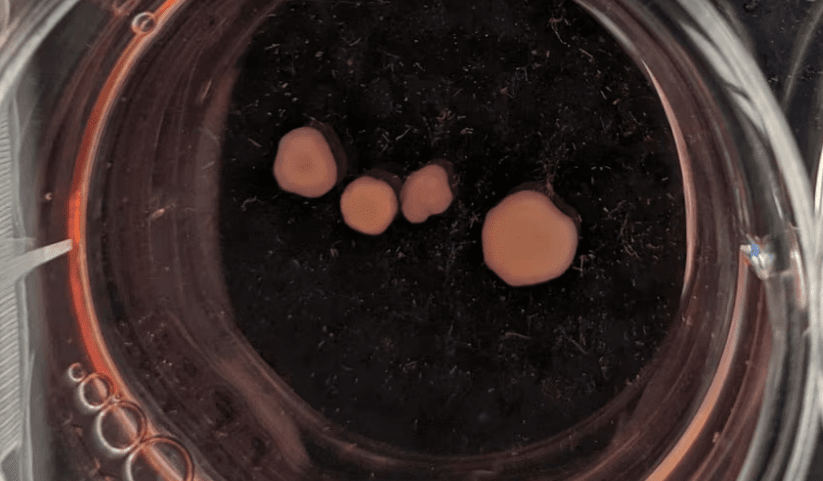

В Художественной галерее Западной Австралии представлен проект Revivification: лабораторно выращенный "мини-мозг" покойного авангардного композитора Элвина Люсьера в реальном времени создает музыку.
 Элвин Люсьер
Элвин Люсьер
Как это работает?
-
Клеточный материал Люсьера (полученный из его крови за год до смерти) превратили в нейроны
-
Затем ученые вырастили церебральные органоиды — упрощённую модель мозга
Органоиды Люсьера
Органоиды Люсьера-
Подключили их к системе из 20 латунных акустических пластин
-
"Мозг" генерирует электрические импульсы, которые преобразуются в звук
"Это не воскрешение сознания, а создание биологического инструмента на основе нейронных паттернов композитора", — приводит The Gardian слова нейробиолога проекта Стюарта Ходжетта.
Что слышат посетители?
Созданная инсталляция производит гипнотическую звуковую среду — хаотичные гулы, ритмичные щелчки и космические гармонии, напоминающие работы самого Люсьера.
А вот для примера музыка, которую создавал композитор:
Дочь Люсьера назвала проект "идеальным продолжением его наследия".
Кто такой Элвин Люсьер?
Элвин Люсьер (Alvin Lucier, 1931–2021) — американский композитор-авангардист, пионер экспериментальной музыки и звукового искусства.
Люсьер стал первым в истории "нейрокомпозитором": в 1965 году создал "Music for Solo Performer" — произведение, где звук генерировался его собственными мозговыми волнами (записанными через ЭЭГ). Это первый случай использования биосигналов в музыке.
Его знаковая композиция I Am Sitting in a Room (1969) демонстрировала магию акустики: многократные перезаписи голоса постепенно превращали слова в гипнотические звуковые волны.
Люсьер десятилетиями исследовал резонанс, эхолокацию и даже тишину, считая их полноправными элементами музыки.















